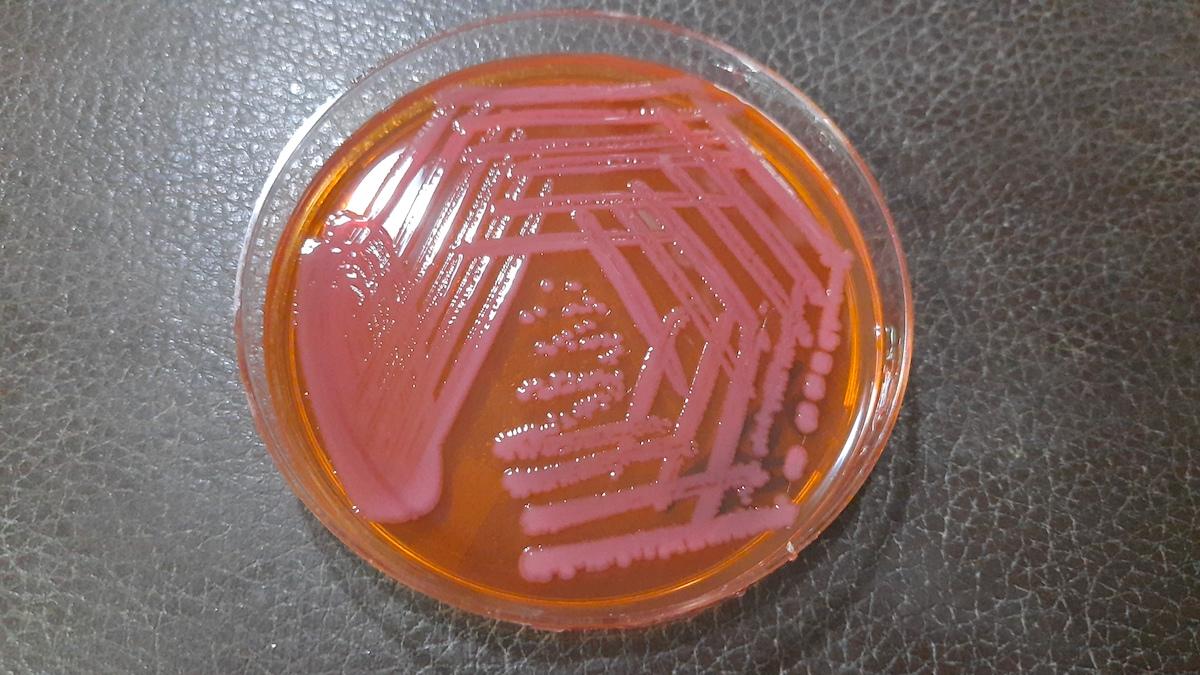

Med hjälp av artificiell intelligens har forskare hittat en ny typ av antibiotika som har förmågan att slå ut en särskilt farlig antibiotikaresistent bakterie.
AI hittade ny typ av antibiotika

I tester på möss har en ny typ av antibiotika visat sig kunna kontrollera tillväxten av en farlig antibiotikaresistent bakterie, det rapporterar CNN.
Kan slå ut antibiotikaresistenta bakterier
I studien testade forskarna även den nya sortens antibiotika på 41 olika stammar av antibiotikaresistenta Acinetobacter baumannii och det fungerade på alla.
Resultatet indikerar att nya sorters antibiotika skulle kunna skräddarsys så att de kan slå ut andra antibiotikaresistenta bakterier.
Innan den ny antibiotikan kan användas på patienter behöver den dock förfinas ytterligare och testas i kliniska studier på människa.
Senaste nytt
Identifierades av AI
Den nya antibiotikan är en förening som har identifierats av artificiell intelligens, AI, och den fungerar på ett sätt som endast hindrar den problematiska patogenen.
Antibiotikan verkade inte döda de många andra, nyttiga, bakterierna som lever på och i våra kroppar, vilket gör den sällsynt snäv och målinriktad.
Om mer antibiotika fungerade på det här sättet skulle bakterier inte bli resistenta, enligt studiens forskare.
AI för läkemedelsupptäckt
Cesar de la Fuente, biträdande professor vid University of Pennsylvanias Perlman School of Medicine, använder också AI för att hitta nya behandlingar.
Han var inte involverad i forskningen om den nya antibiotikan men tycker att den är otroligt lovande.
Enligt honom ökar det här sättet att hitta nya läkemedel och minskar rejält den tid det tar att sortera igenom tusentals lovande substanser.
“Jag tror att AI, som vi har sett, kan tillämpas framgångsrikt i många domäner, och jag tror att läkemedelsupptäckt är något av nästa forskningsområde”, säger han till CNN.
En professionell patogen
I studien fokuserade forskarna på bakterien Actinetobacter baumanii, som finns på sjukhus och i andra hälso- och sjukvårdsmiljöer.
Den fäster på ytor som dörrhandtag och expeditionsdiskar och kan ta bitar av DNA från andra organismer som den kommer i kontakt med och kan därför inkorporera gener som hjälper den att bli resistent mot de läkemedel som används.
“Det är vad vi i laboratoriet kallar en professionell patogen”, säger en av forskarna bakom studien Jon Stokes, till CNN.
Han är biträdande professor i biokemi och biomedicinsk vetenskap vid McMaster University i Hamilton, Ontario, USA.
Actinetobacter baumanii orsakar svårbehandlade hud- blod- eller luftvägsinfektioner och en nyligen genomförd studie på sjukhuspatienter som infekterats med dessa bakterier visade att en av fyra avlidit inom en månad efter diagnos.
Vill du läsa de senaste nyheterna om ekonomi och Life Science? Så här enkelt får du vår kostnadsfria nyhetstjänst.
Läs mer: Allt fler vill utveckla läkemedel med hjälp av AI
Läs mer: Växtgift kan bli ny sorts antibiotika

Reporter på Dagens PS med fokus på bland annat Life Science, hälsa och hållbarhet.

Reporter på Dagens PS med fokus på bland annat Life Science, hälsa och hållbarhet.








